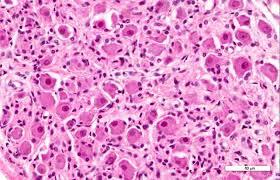
Ganglios Nervisos

-
Las bacterias eran y son uno de esos seres unicelulares y son el principio de la vida. En ellas tambien encontramos el principio del procesamiento de informacion. A pesar de su sencillez, eran seres que demostraban una primitiva capacacidad de hacerlo.
-
La aparición del tejido especializado de seres unicelulares la evolución paso a los seres pluricelulares. Esta expansión en el número de células fue un trabajo en conjunto mediante mutaciones, conllevo la aparición de diferentes funciones.
-
Esas células neuropiteliales, en el curso de la evolución, dieron paso a neuronas primitivas. Estas neuronas no tenían una diferenciación clara y funcional de axones y dendritas. Además, el problema de los primeros seres que dispusieron de estas neuronas no estaban organizadas de una manera tan efectiva como la nuestra.
-
La evolución empezó a poner en orden en esa maraña de neuronas, A nivel individual, las nauronas comenzaron a disponer de su organización característica (axones para transmitir impulsos, dendritas para recibir impulsos). A nivel de conjunto, en esa maraña "sin sentido" aparecieron los ganglios o núcleos, esto es, pequeñas agrupaciones neuronales con unidad funcional.
-
Un ganglio fue elegido por la seleccion naturas para volverse el principal centro de proceamiento de la información: el ganglio encefálico. Se trataba de un ganglio especialmente importante por ser el primer ganglio que entraba en contacto con el nuevo medio cuando éramos seres reptiles. Cuando las lombrices reptan, la cabeza es lo primero que llega a lo nuevo.
-
La evolucion dio lugar al filo de los cordados, los seres vivios que disponen de una cuerda dorsal compuesta por neuronas formando diversos núcleos. Esta cuerda paste del ganglio encefalico y alberga los cuerpos de neuronas que transmiten la información al resto de ganglio u órganos. Aunque los cordados son animales filogenéticamente antiguos, este cordón de neuronas ha evolucionado en complejidad desde su origen.
-
Antes de que surgiera nuestro cerebro tal y como lo conocemos, el ganglio encefálico de aquellas lombrices siguió creciendo en complejidad y se conformaron diversas unidades que ahora conocemos como tronco del encéfalo, diencéfalo y cerebelo. conjunto de núcleos y conexiones entre ello. Estos primeros centros de procesamiento siguen presentes en especies evolutivamante avanzadas como nosotoros, los humanos.
-
Los hefimerios cerebrales son la parte más nueva de nuestro sistema nervioso. Están formados por núcleos y lo haces que unen esos núcleos. La corteza cerebral es uno de ellos. Es la organización neuronal compleja en capas y columnas que se arruga dentro de nuestro cráneo y es orígen de funciones de procesamiento complejas como la memoria, el lenguaje, la imaginacion, la consiencia, etc. Pero su aparición no fue repentina y no es patrimonio exclusivo nuestro.
-
Investigadores de la ciudad de Arizona han encontrado en China el fósil de un antropodode hace 520 millones de años en el que se aprecia notoriamente bien consevado su cerebro, resulta ser el más antiguo jamás descubirto.
-
McCulloch y Pitss dio origen a los modelos conexionista definiendo formalmente la neurona en 1943 con una maquina binaria con varias entradas y salidas.
-
Warren McCulloch y Walter Pitts crearon un modelo que señalo el camino para la investigacion de redes neuronales se divida en dos enfoques distintos. Un enfoque centrado en los procesos biologicos en el cerebro y el otro se centró en la aplicación de redes neuronales para la inteligencia artifcial.
Plan projects on a visual timeline
Map milestones, phases, deadlines, and key events in one place so the sequence is easier to see and share. Timetoast is a timeline maker for work, school, research, and stories.